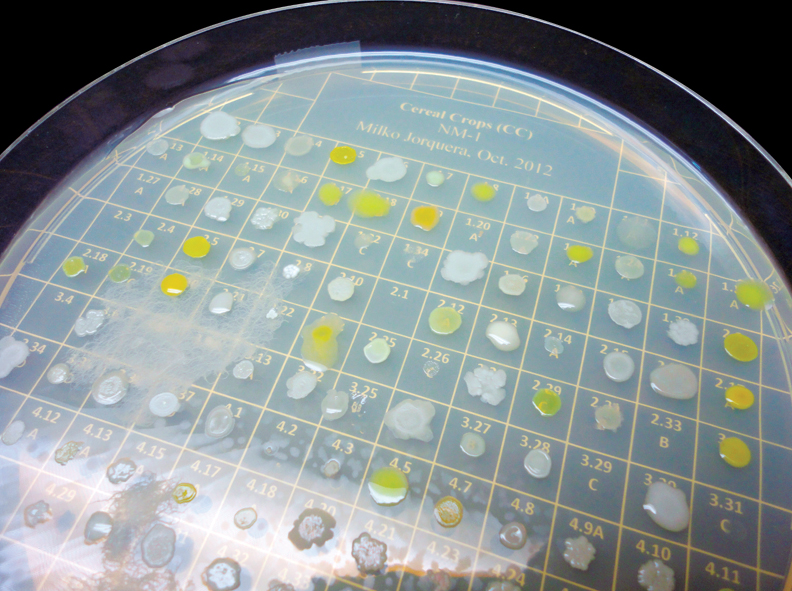

Primera cosecha en Chile de almendros en súper alta densidad
En un contexto en que algunas especies frutícolas tradicionales ven mermada su rentabilidad, el déficit hídrico se acentúa y la mano de obra escasea y se encarece, Agromillora presentó una opción de manejo altamente mecanizada. Con el uso de variedades españolas autofértiles y de floración tardía sobre un portainjerto de bajo vigor es posible el uso eficiente del agua por una parte, y por otra llevar el almendro a otras zonas, incluso más frías donde antes ni siquiera se consideraba. Sorprendió el número de asistentes, pero no es extraño el interés por conocer esta nueva tecnología que posibilita precocidad, alta productividad, ingresos atractivos, escapar de las heladas y optimizar el recurso humano, entre otras ventajas.




Con una concurrencia que sobrepasó todo lo esperado, Agromillora realizó el 20 de febrero de 2020 un Día de Campo con la primera Cosecha de Almendro en Alta Densidad en un huerto comercial en Chile. El evento se realizó en el fundo Cunaquito, de Agrícola Tinguiririca, comuna de Santa Cruz en la Región de O’Higgins.
En la presentación técnica a cargo de Mauricio Zúñiga, Responsable Técnico Comercial de Agromillora Sur, se dieron a conocer las principales características técnicas del huerto. En este se estableció la variedad Guara sobre portainjerto Rootpac 20, el 17 de noviembre de 2017, en un marco de plantación a 3,5 x 1 m, con 2.857 plantas por hectárea. Se trata de un seto o muralla frutal en dos dimensiones, con un ancho de 70-80 cm y una altura que llegará a entre 2,5 y 2,7 metros.
UNA GRAN VENTAJA: MECANIZACIÓN DE LA PODA Y LA COSECHA
Tanto la poda como la cosecha se llevan a cabo en forma totalmente mecanizada. El rendimiento calculado para esta primera cosecha comercial, a los 2 años y tres meses, será de 600 a 700 kg de pepa/ha, quedando por confirmar con el informe de la planta procesadora. La cifra se encuentra en el rango esperable, indicó Zúñiga, de 500 a 800 kg en la tercera hoja; 800 a 1.500 kg en la cuarta y 1.500 a 2.500 kg de pepa/ ha en plena producción a partir de la quinta.


Entre los aspectos que interesaba comprobar estaba el porcentaje de fruta que la máquina bota al suelo. Este alcanzó un 4,7%, un buen resultado si se considera que la misma cosechadora en España pierde un 6 a 10% de almendras.
–En el futuro, dependiendo del precio y el costo de la mano de obra, se debe evaluar si conviene o no recoger, pero hay que considerar que las empresas fabricantes de máquinas cosechadoras se están tomando esta nueva alternativa muy seriamente y lo más probable que hagan mejoras para bajar al mínimo estas perdidas– reflexionó el Responsable Técnico Comercial de Agromillora.
Asimismo, importaba determinar si se provocaba algún daño en los árboles, ya que el equipo los golpea para sacar la fruta. Aunque se detectaron algunos machucones, quiebre de unas pocas ramillas y dardos, que se podrían evitar con mejor manejo y timing de podas, el impacto resultó poco significativo, quedando la inmensa mayoría de los dardos en muy buenas condiciones para el año siguiente.


Interesante es también recalcar que, al hacer la cosecha con este tipo de máquinas automotrices, la fruta no toca el suelo ni se contamina con patógenos ni pesticidas. Por otro lado, se evita la enorme nube de polvo de la cosecha mecánica tradicional, que ya genera graves inconvenientes ambientales, por ejemplo, en California.
NOTORIO IMPACTO EN LAS APLICACIONES Y AHORRO CONSIDERABLE DE AGUA DE RIEGO
Las ventajas descritas para el sistema en alta densidad incluyen una mayor eficiencia de la fertilización y de los tratamientos.
–Como los árboles son pequeños, en España hemos visto que se pueden hacer las aplicaciones hasta con una moto de cuatro ruedas; asimismo se reduce la madera estructural, se aproximan los frutos a los canales de nutrición, se reducen las zonas sombreadas y se mejora la accesibilidad para las diferentes operaciones de cultivo, ya sean manuales o mediante el uso de máquinas –comenta Zúñiga–. El impacto es muy notorio en el riego: si para el manejo normal del almendro en países como Chile, Australia o EE.UU. se necesitan del orden de 10.000 a 12.000 m3/ha/año, de acuerdo a los datos recogidos en el fundo Cunaquito los requerimientos se situarían en torno a 6.500 a 7.000 m3, para sacar sobre 2.000 kg de pepa/ha.

Los costos reales de inversión se cuantificaron en torno a los US$17.000/ha en nuestras condiciones, incluyendo el material vegetal, riego, preparación de suelos, poda y plantación. El costo de manejo en los dos primeros años se sitúa alrededor de los US$2.850/ha/año y ya en plena producción rodea los US$4.200 a 4.500/ha/año, considerando secado y flete hasta la planta. Como referencia, con los retornos del año 2018 por kilo de pepa, una producción de 2.000 kg/ha significaría ingresos brutos del orden de los US$10.000 a 12.000/ha al año.
ENSAYOS LLEGAN HASTA EL SUR: LA INNOVACIÓN EN LA MENTE DE LOS PRODUCTORES
Agromillora, el mayor productor de portainjertos de cerezo del país, dispone también en Chile de distintas variedades de almendro, además de Guara: Soleta, Isabelona, Avijor, Penta y Vialfás, con épocas de floración tardía y cosecha escalonadas. Adicionalmente cuenta con el portainjerto de bajo vigor Rootpac 20, de su autoría y propiedad, el más indicado y probado para este tipo de plantaciones. Actualmente, efectúa evaluaciones en súper alta densidad, en distintas localidades del centro/sur de Chile: Rengo, San Rafael, Bulnes, Los Ángeles, Angol, Collipulli, Traiguén, Cholchol y Paillaco.






–En el mediano plazo –señala Antonio Fuentes, Zonal Centro/Sur de Agromillora–, la segunda fase de los ensayos será probar con algunas variedades que ya daremos a conocer, pero esta vez autorradicadas, es decir sin portainjertos, y exclusivamente para secano, o bien, eventualmente para utilizar capacidad ya instalada (por ejemplo, pivotes de riego o carretes). Se tratará de plantas multiplicadas in vitro, lo que nos permitirá habilitar huertos homogéneos en calidad y genética, sin duda más económicos de establecer, en lugares donde aseguremos una pluviometría superior a los 400-500 mm anuales. Se busca rentabilizar esos suelos por sobre los cereales o la ganadería de secano; por ejemplo, desde Chillán-Los Ángeles hacia el sur.
–En España esto está recién partiendo, y en 2020 se realizará la primera cosecha de los ensayos, que seguiremos y difundiremos con mucho interés –agrega–. Dependiendo de la sensibilidad que se vea en cuanto a plagas y enfermedades, se podría incluso pensar en la opción de huertos orgánicos o ecológicos, lo que entregaría más valor al producto para compensar una producción menor al estar en secano. El sistema ha sido muy atractivo de momento entre los agricultores del centro/sur, acostumbrados ya a la total mecanización de muchos de sus cultivos (trigo, maíz, papa, remolacha, etc.). Si logramos determinar las macrozonas, y las variedades que mejor se adapten a ellas, habremos contribuido con una muy buena alternativa para quienes están haciendo hoy la transición desde los cultivos tradicionales hacia opciones de fruticultura, como la que ofrece actualmente el avellano.
Por su parte, Sergio de Rojas, Gerente General de Agromillora Sur, invita a desmitificar el tema de las variedades:


–Nos hemos ido quedando con una sola en el caso del almendro –argumenta el ejecutivo–. La Nonpareil es la top de línea, pero tenemos que ir más allá. Si analizamos los usos en EE.UU. vemos que, por ejemplo, un porcentaje importante de la almendra se va a “sustitutos lácteos” y otros productos, como yogurt e incluso queso. Y la gente no se fija ni distingue si es Nonpareil o cualquier otra variedad.
El Gerente General de la filial en Chile del grupo Agromillora calificó así la actividad demostrativa:
– Un rotundo éxito. En Agromillora trabajamos con dos pilares fundamentales, la pasión y el compromiso. Se nota hoy con la convocatoria. Mi recomendación a los productores interesados y lo que tenemos impregnado en nuestro equipo es “primero probar”. Así, en Chile establecimos ya más de 10 ensayos en distintas variedades, densidades y zonas. Con esos ensayos en alta densidad, podemos demostrarles que sí se puede y que los vamos a acompañar en esto. La producción se está moviendo al sur, por el tema de la sequía, disponibilidad de buenos suelos y los ya históricos bajos precios de commodities como los cereales, la remolacha o la leche. Hay personas que están empezando, ¡qué bueno que la innovación ya se encuentra en la mente de los agricultores!
HERNÁN MARTINO, EL ANFITRIÓN
DECÍAN “NO VA A RESULTAR”, PERO VA A SER MUCHO MÁS EFICIENTE QUE EL SISTEMA CONVENCIONAL


–Los costos nos empezaron a comer y se tomó la decisión en conjunto con el dueño de buscar una alternativa innovadora, siempre pensando en algo mecanizado, para no depender tanto de la mano de obra.
En esa búsqueda, los almendros parecían un cultivo atractivo, pero había un problema con las variedades más conocidas.
–En esta zona con una Nonpareil me van a caer varias heladas y productivamente no me va a funcionar. ¿Y cómo escapar de eso? Hoy día existen variedades de floración más tardía, como las españolas, con la gran ventaja de que son autopolinizantes, y esto permite establecer los huertos en monobloque. Era la alternativa para poder salir de la floración anticipada de los almendros norteamericanos.
Hernán Martino había tenido la experiencia profesional de trabajar con olivos en alta densidad, de manera que no sintió temor de probar la ultra alta densidad en esta otra especie frutal.
–Recibí, y Agromillora más que yo, obviamente, las críticas del mundo tradicional de los almendros: “no va a resultar”, decían. Yo creo, y por lo que he visto en España, donde llevan ya 8 años, que esto sí va a funcionar. Va a ser mucho más eficiente que el sistema convencional. En España algunos huertos han superado los 2.500 kg de pepa/ha, y muchos sobrepasarán los 3.000 kg/ha con los manejos apropiados. El proyecto yo lo evalué, financieramente, con 2.500 kg de pepa y un retorno de 4,5 dólares por kilo.
–¿Cómo ves el tema de la comercialización? Hay dudas respecto a la demanda por estas variedades…
–Me encontré con muy buena respuesta en mi primera cosecha. Ya la tengo vendida a una exportadora y había otra que mostró harto interés. La parte comercial no la veo como un gran tema.
PAULO ESTRADA, DE EXPORTADORA HUERTOS DEL VALLE
SE GENERA UNA VENTANA SÚPER ATRACTIVA PARA ÁREAS NUEVAS DE PLANTACIÓN


–Las variedades americanas hoy están limitadas a ciertas zonas geográficas. La Nonpareil florece el 15 de agosto e incluso antes, entonces hay alto riesgo de heladas. Los cultivares españoles nos abrirían nuevas zonas geográficas de plantación porque presentan floraciones más tardías, además al ser autofértiles y no necesitar de abejas. Por lo tanto se genera una ventana súper atractiva para áreas nuevas de plantación. Súmale a eso que es un cultivo que se puede mecanizar en un 100%.
–Existe cierta inquietud respecto de la factibilidad del procesamiento, porque estas variedades son de cáscara dura.
–Si bien las máquinas que se usan en nuestro país son estadounidenses, diseñadas para craquear variedades norteamericanas, de cáscara más blanda, tú en la planta puedes cambiar los rodillos. Eso ya existe, nosotros lo hacemos. La única limitación se relaciona con la baja producción actual de estas variedades, que generalmente lleva a desplazarlas al final del proceso. Pero si fueran volúmenes mayores el tema se hace mucho más atractivo y comercialmente podría variar.
JUAN PABLO MIR, DE SIGDOTEK
ESTE TIPO DE COSECHA SE ESTÁ MASIFICANDO


–¿Cuál es la superficie mínima para justificar económicamente una cosechadora?
–Siempre la máquina se va a pagar, pero para que ello ocurra en un plazo medianamente corto creo que debieran ser unas 150 a 200 ha. Sin embargo, hay prestadores de servicio muy buenos, que son una proporción súper grande de nuestros clientes y tienen cosechadoras de olivos. Nosotros contamos con una persona encargada de esta tecnología, con experiencia en Chile, Portugal y Francia; quien quiera mayor información, por compra o para entender algo del negocio, estamos por ayudar y aportar, así es que pueden llamar y los asesoramos.
CLAUDIO MORALES, DE VIA WINES
LOS QUE ESTAMOS ACÁ QUEREMOS DAR UN VUELCO EN LO QUE HACEMOS


–Nosotros somos viticultores, básicamente, pero la intensión de la compañía es tener un área nueva de expansión, dadas las realidades del mercado y las demandas de negocios de alta rentabilidad. Indiscutiblemente con los precios y los rendimientos que vimos en las charlas, los retornos económicos son altamente interesantes. Todos quienes estamos reunidos acá queremos dar un vuelco a lo que hacemos: diversificar, mecanizar y dar un plus a los cultivos más decaídos en cuanto a retornos.
–¿Qué variedades están probando?
–Tenemos cinco variedades, plantadas en una superficie de 0,7 ha en diciembre del año pasado, a 3 x 1 m [densidad de 3.300 plantas/ha]. Vegetativamente están espectaculares, andan súper bien. Lo que hay que ver en adelante es la variable climática: por lo que entiendo son los almendros de floración más tardía que hay en Europa, y en la variable heladas cuatro días o una semana de retardo hacen la diferencia.
CONTACTO:
Mauricio Zuñiga B. mzuniga@agromillora.com
Antonio Fuentes O. afuentes@agromillora.com
